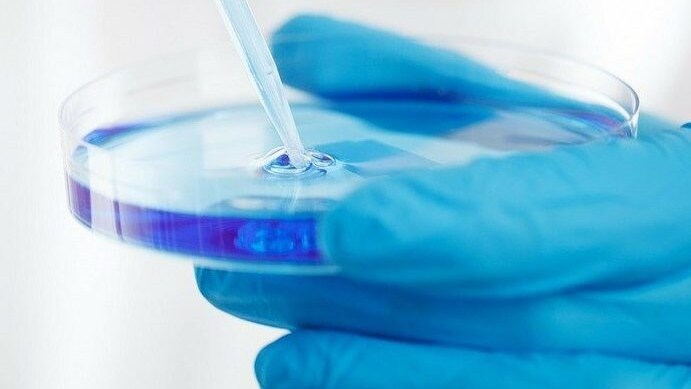
Immagine

Giampiero Valenza
Sono un giornalista professionista. Laureato in Scienze della Comunicazione con Master di I livello in Antropologia filosofica, cromonologia e tecniche investigative avanzata e Master di II livello in Scienze Criminologiche. Ho lavorato per il notiziario Salute e Benessere dell’agenzia di stampa ANSA e per Verde, l’inserto del martedì specializzato in sviluppo sostenibile, del quotidiano Corriere Romagna. Ho scritto per il freepress Leggo e il quotidiano della Repubblica di San Marino, La Tribuna sammarinese. Sono stato il responsabile del dipartimento di comunicazione e giornalismo ambientale del CESAB e componente del gruppo di ricerca Biomedia. Ho scritto il volume “Etica e sanità: linee guida per medici e giornalisti” (insieme a Orfeo Notaristefano) e una collana di quaderni di comunicazione ambientale.
[ALTRO]
Sono un giornalista professionista. Laureato in Scienze della Comunicazione con Master di I livello in Antropologia filosofica, cromonologia e tecniche investigative avanzata e Master di II livello in Scienze Criminologiche. Ho lavorato per il notiziario Salute e Benessere dell’agenzia di stampa ANSA e per Verde, l’inserto del martedì specializzato in sviluppo sostenibile, del quotidiano Corriere Romagna. Ho scritto per il freepress Leggo e il quotidiano della Repubblica di San Marino, La Tribuna sammarinese. Sono stato il responsabile del dipartimento di comunicazione e giornalismo ambientale del CESAB e componente del gruppo di ricerca Biomedia. Ho scritto il volume “Etica e sanità: linee guida per medici e giornalisti” (insieme a Orfeo Notaristefano) e una collana di quaderni di comunicazione ambientale.
;Resize,width=727;)
;Resize,width=727;)
;Resize,width=727;)
;Resize,width=727;)
;Resize,width=727;)
;Resize,width=727;)
;Resize,width=727;)
;Resize,width=727;)
;Resize,width=727;)
;Resize,width=727;)
;Resize,width=727;)
;Resize,width=727;)
;Resize,width=727;)
;Resize,width=727;)

;Resize,width=727;)
;Resize,width=727;)
;Resize,width=727;)
;Resize,width=727;)